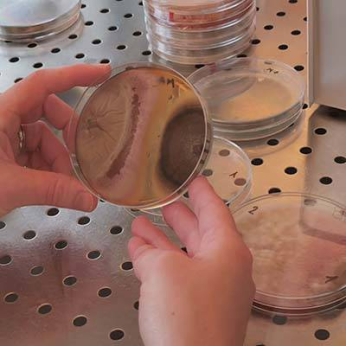

INRAE
Education - Research
Information
Type d'entreprise
Enseignement - Recherche
Langue de correspondance
FRANCAIS
Activity
INRA is a public scientific and technological centre working for the production, dissemination and enhancement of scientific knowledge derived from agronomic research. The Pays de la Loire centre is focusing on the knowledge, expertise and innovation for the sustainable management and quality of vegetable crops and animal breeding as weel as on the quality of bio-sourced feed and materials.
Activity field
- Teaching - formation
- Teaching - formation
Activity field
Sectors concerned
ArboricultureCider MakingVegetable CropsHorticulture et PépinièresNouvelles FilièresSeeds and seedlingsWine Growing
Markets
Export
Present only on the French market